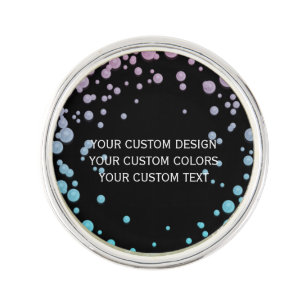
Your Custom Design Here - Lapel Pin

Popular Blank Lapel Pins
125 results
Create Your Own - Design a Custom Lapel PinMore like this
Sale Price $21.21. Original Price $24.95. Comp. value
Create Your Own white Gold Finish Lapel PinMore like this
Sale Price $20.83. Original Price $24.50. Comp. value
Create Your Own white Save The Date Gold Finish Lapel PinMore like this
Sale Price $22.27. Original Price $26.20. Comp. value
Create Your Own white Gold Finish Lapel PinMore like this
Sale Price $22.27. Original Price $26.20. Comp. value
Custom Farm Business Promotional Logo Lapel PinMore like this
Sale Price $18.53. Original Price $21.80. Comp. value
Modern, Minimalist, Elegant and Customizable Silver Finish Lapel PinMore like this
Sale Price $20.62. Original Price $24.25. Comp. value
Modern, Minimalist, Elegant and Customizable Lapel PinMore like this
Sale Price $20.62. Original Price $24.25. Comp. value
custom, unique, sleek & minimalist hershey®'s kiss gold finish lapel pinMore like this
Sale Price $20.49. Original Price $24.10. Comp. value
custom, unique, sleek & minimalist hershey®'s kiss lapel pinMore like this
Sale Price $20.49. Original Price $24.10. Comp. value
custom, unique, sleek & minimalist lapel pinMore like this
Sale Price $20.49. Original Price $24.10. Comp. value
Blank For You To Customize - Lapel PinMore like this
Sale Price $21.21. Original Price $24.95. Comp. value
BLANK Your Design Here - Lapel PinMore like this
Sale Price $21.21. Original Price $24.95. Comp. value
Blank - Create Your Own Custom Lapel PinMore like this
Sale Price $21.21. Original Price $24.95. Comp. value
Create Your Own Custom Lapel PinMore like this
Sale Price $21.21. Original Price $24.95. Comp. value
Redesign from Scratch - Create a Custom Lapel PinMore like this
Sale Price $21.21. Original Price $24.95. Comp. value
custom, unique, sleek & minimalist hershey®'s kiss silver finish lapel pinMore like this
Sale Price $23.72. Original Price $27.90. Comp. value
custom, unique, sleek & minimalist gold finish lapel pinMore like this
Sale Price $20.49. Original Price $24.10. Comp. value
Create Your Own Custom Lapel PinMore like this
Sale Price $21.21. Original Price $24.95. Comp. value
Create Your Own Personalized Silver Finish Lapel PinMore like this
Sale Price $21.21. Original Price $24.95. Comp. value
Custom Faux Gold Monogram Elegant Template Finish Lapel PinMore like this
Sale Price $19.47. Original Price $22.90. Comp. value
custom, unique, sleek & minimalist lapel pinMore like this
Sale Price $20.49. Original Price $24.10. Comp. value
Create Your Own Custom Lapel PinMore like this
Sale Price $21.21. Original Price $24.95. Comp. value
Create Your Own Silver Finish Lapel PinMore like this
Sale Price $21.21. Original Price $24.95. Comp. value
Create Your Own - Silver Finish Lapel PinMore like this
Sale Price $21.21. Original Price $24.95. Comp. value
Create Your Own Custom Personalized Lapel PinMore like this
Sale Price $21.21. Original Price $24.95. Comp. value
Create a Custom Personalized Lapel PinMore like this
Sale Price $21.21. Original Price $24.95. Comp. value
Create Your Own Custom Image Lapel PinMore like this
Sale Price $21.21. Original Price $24.95. Comp. value
Create Your Own Custom Lapel PinMore like this
Sale Price $21.21. Original Price $24.95. Comp. value
Create Your Own Custom Personalized Lapel PinMore like this
Sale Price $21.21. Original Price $24.95. Comp. value
Create Your Own Custom Lapel PinMore like this
Sale Price $21.21. Original Price $24.95. Comp. value
Personalized text and photo template lapel pinMore like this
Sale Price $18.53. Original Price $21.80. Comp. value
Your Design Here - Personalized Lapel PinMore like this
Sale Price $21.21. Original Price $24.95. Comp. value
Design Your Own Custom Lapel PinMore like this
Sale Price $21.21. Original Price $24.95. Comp. value
Replace Image or Personalize - Lapel PinMore like this
Sale Price $21.21. Original Price $24.95. Comp. value
Personalized Vintage Aged to Perfection Gunmetal Finish Lapel PinMore like this
Sale Price $18.53. Original Price $21.80. Comp. value
Create Your Own Customized Lapel PinMore like this
Sale Price $21.21. Original Price $24.95. Comp. value
Create Your Own Custom Lapel PinMore like this
Sale Price $21.21. Original Price $24.95. Comp. value
Create Your Own Custom Personalized Lapel PinMore like this
Sale Price $21.21. Original Price $24.95. Comp. value
Your Design Here - Create Your Own Lapel PinMore like this
Sale Price $21.21. Original Price $24.95. Comp. value
Create Your Own - Star Glitter Lapel PinMore like this
Sale Price $21.21. Original Price $24.95. Comp. value
Create Your Own Silver Finish Lapel PinMore like this
Sale Price $21.21. Original Price $24.95. Comp. value
Redesign from Scratch - Create Your Own Lapel PinMore like this
Sale Price $21.21. Original Price $24.95. Comp. value
Your Custom Design Here - Lapel PinMore like this
Sale Price $21.21. Original Price $24.95. Comp. value
Create Your Own - Custom Design Lapel PinMore like this
Sale Price $21.21. Original Price $24.95. Comp. value
I Heart Name Silver Finish Lapel PinMore like this
Sale Price $18.53. Original Price $21.80. Comp. value
Keep Calm and Carry On - Create Your Own Lapel PinMore like this
Sale Price $18.53. Original Price $21.80. Comp. value
Create Your Own Completely Customized Lapel PinMore like this
Sale Price $21.21. Original Price $24.95. Comp. value
Unique Personalized Black and White Name Monogram Gunmetal Finish Lapel PinMore like this
Sale Price $18.53. Original Price $21.80. Comp. value
Faux Gold Monogram Elegant Template Modern Finish Lapel PinMore like this
Sale Price $19.47. Original Price $22.90. Comp. value
STRAIGHT OUTTA - add your text here/create own PinMore like this
Sale Price $18.53. Original Price $21.80. Comp. value
Create Your Own - Your Custom Design Gunmetal Finish Lapel PinMore like this
Sale Price $21.21. Original Price $24.95. Comp. value
Create Your Own Brown Gold Finish Lapel PinMore like this
Sale Price $24.44. Original Price $28.75. Comp. value
Search Feedback
If you need help or have a question for Customer Service, please visit our Help Center
Recently Viewed Items